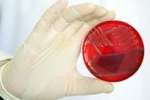
В эпидемиях виноваты не супер-бактерии, а плохая гигиена

Тег: Супер

Откуда появились «супервши»
Заразиться педикулезом можно где угодно. Избавиться от этих паразитов становится все сложнее. Медики говорят о появлении «супервшей», на которых обы...

В одном из супермаркетов Ставрополя уничтожили продукцию, у которой не совпадала маркировка
По данным пресс-службы краевого Россельхознадзора, 21 июня этого года в одном из супермаркетов Ставрополя специалисты обнаружили фрукты, информация на...

Автомобиль, который врезался в витрину супермаркета в Ставрополе, оказался без водителя
Автомобиль, который врезался в витрину супермаркета в Ставрополе оказался без водителя. Напомним, что в краевом центре утром 30 марта машина врезалась...

Суперфуды рядом с нами
Всем знаменитым импортным суперфудам можно найти аналоги среди обычных привычных продуктов. Так семена чиа можно заменить семенами льна и кунжута. Шип...

Не стоит расходоваться на супершампуни
Не старайтесь покупать дорогие шампуни, кондиционеры и ополаскиватели, доверяя аннотациям рекламы и надписей на пузырьках. Нет таких чудесных средств,...

Суперпродукт лук
Лук не просто является продуктом, без которого многие блюда просто не приготовишь. Это настоящее средство для исцеления. Человек культивировал лук бол...

Ставропольские гандболистки одержали первую победу в суперлиге
Женская команда по гандболу «Ставрополье-СКФУ» из Ставрополя выиграла у АГУ-АдыИФ из Майкопа со счётом 38:29 в шестом туре чемпионата России среди жен...

В Ставрополе открывается новый цифровой супермаркет DNS
В Ставрополе открывается новый цифровой супермаркет DNS...

Депутаты поздравили ставропольских гандболисток с выходом в российскую женскую суперлигу
Во встрече со спортсменками и тренерами команды «Ставрополье-СКФУ» приняли участие первый заместитель председателя Думы Ставропольского края Дмитрий С...

Топ-20 суперфруктов, приносящих наибольшую пользу организму
Звания суперфрукта удостаиваются только те, в которых огромное количество и витаминов, и клетчатки, и антиоксидантов, и минералов...

Житель Нефтекумска пытался украсть из супермаркета две тележки с едой и алкоголем
В Нефтекумске полиция задержала местного жителя, который пытался украсть из супермаркета две тележки со спиртным и продуктами...

Биологи попытаются уничтожить одну из самых опасных супербактерий
Ученые работают над первой вакциной против больничной инфекции, вызванной Clostridium difficile (C. diff), рассказывает ABC News. Данная бактерия про...

В супермаркетах «Флагман» прокуратура выявила нарушения
В управлении по надзору за исполнением федерального законодательства проведена проверка доводов, изложенных в статье «Таракан в подарок к пирожку», оп...

Продуктовые тележки в супермаркетах грязнее общественных туалетов
Американские ученые после исследований пришли к выводу, что продуктовые корзины и тележки супермаркетов ничуть не чище общественных туалетов...

Медицина будущего: супертонкие сенсоры, имплантируемые прямо в тело
Японские ученые создали гибкие электрические цепи толщиной в одну пятую пищевой пленки и с весом, не превышающим вес пера, сообщает AFP...

Собрались в супермаркет? Поешьте перед выходом из дома
Ученые университета Корнелл обнаружили, что перед походом в супермаркет следует поесть. В эксперименте участвовали 62 добровольца. Половина участников...

Арабский суперкар можно будет приобрести за 3,5 миллиона долларов
Озвучена стоимость арабского суперкара, который будет готов поразить собственного собственника и его попутчиков блеском золота и бриллиантов...

В Ставрополе выберут «супербабушек»
С 10 сентября по 2 октября администрация Ставрополя проводит обычный конкурс «Моя супербабушка», посвященный Интернациональному Дню пожилых жителей на...

Ученые нашли суперантитело, которое не только спасает от вирусов гриппа
О том, что грипп коварен, знают все. Можнож перебрать весь алфавит штаммов гриппа, а он возвратится через год в новеньком обличии, чтоб смонтировать...

Звезда «Супермена» стал отцом
Знаменитый южноамериканский актер Брэндон Рут, прославившийся, благодаря роли в кинофильме «Возвращение супермена» в первый раз стал папой...

Состоялся анонс гибридного суперкара Porsche
В Нью-Йорке прошло закрытое мероприятие, на котором компания Porsche показала новейший вариант гибридного суперкара 918 Spyder...

Супермодель Наталья Водянова ночует в палатке
Известная во всем мире супермодель Наталья Водянова теснее наиболее 2-ух суток находится в пережившем ужасное наводнение Краснодарском крае с гуманита...

Гринпис приучает супермаркеты к порядку
Соучастники организации Гринпис устроили беспрецедентную акцию в Москве и Петербурге. Они решили направить внимание на супермаркеты и торгашеские сети...

Появился новый супертелефон
Новенькая модель Verizon Galaxy Nexus представлена на базаре. Стоимость гаджета сочиняет 299,99 бакса. При покупке телефона нужно заключить договор на...

Новый суперкар от компании Nissan
Прежставители компании Nissan дарили новейший супер автомобиль GT-R. Новость будет вооружена спорт-пакетом Track Pack, разработанным компанией Nissan...

Ученые вывели новый сорт суперкапусты
Благодаря усердиям ученых из Института пищевых исследований и Центра Джона Иннеса в Норидже возникла новенькая капуста. Суперброкколи, которой дали за...

Медики разработали супер-рацион для тех, кому за 40
Чтобы предотвратить развитие почти всех болезней, сопряженных с возрастом, необходимо соблюдать необыкновенную диету, рекомендуют южноамериканские пр...

Найдено уязвимое место супербактерий
Английские ученые говорят, что им удалось отыскать уязвимое место супербактерий метициллин-резистентного золотистого стафилококка(МРЗС), которые явля...

Антибиотики делают ребенка беззащитным перед супербактериями
Детям лучше не предоставлять лекарства. Это увеличивает риск появления в организме устойчивого золотистого стафилококка, показало изыскание, в ходе ко...

Найдено "супер-антитело" для создания универсальной вакцины от гриппа
Ученые стоят на пороге создания уникальной универсальной вакцины против всех штаммов гриппа. До сих пор приходилось ежегодно бороться с новыми мутация...

Супергель способен вернуть певцам голос
Инъекции особого геля обещают помочь певцам, потерявшим частично голос. Как показало исследование, он расслабляет связки, находящиеся в напряжении из-...
В эпидемиях виноваты не супер-бактерии, а плохая гигиена
Эпидемия кишечных заболеваний в Европе, вызванная штаммом кишечной палочки 0104:H4 и спровоцировавшая смерть более 50 человек, наложила сильный отпеча...

Мясо в супермаркетах заражено бактериями, устойчивыми к антибиотикам?
Американские эксперты обнаружили большое количество бактерий в мясе, продающемся в супермаркетах и мясных лавках. И большая часть этих микроорганизмов...

"Суперфан" киевского "Динамо" пнул судью после матча
Болельщик киевского "Динамо" по прозвищу Парамон, которого часто называют "суперфаном" украинской команды, пнул одного из арбитров матча 1/4 финал...

Финский супертяж намерен отобрать титул у Александра Димитренко
Финский супертяж Роберт Хелениус, одержавший 15 побед и 0 поражений, и его команда Sauerland Event намерены организовать бой с Александром Димитренко...

Помидоры – новый супер-продукт!
Американские ученые утверждают, что помидоры исключительно полезны для нашего здоровья, поскольку их употребление снижает риск развития таких заболева...

Кристен Стюарт отвергла Супермена!
Популярная актриса Кристен Стюарт отвергла Супермена! Как рассказала представителям СМИ сама Стюарт, режиссер Зак Снайдер, предложил ей сыграть возлюб...

Супермен возвращается!
Знаменитый американский режиссер – Зак Снайдер, снимающий картину «Возвращение Супермена-2: Человек из стали», признался, что уже давно нашел кандидат...

Свиной грипп подарил нам супер-иммунитет!
Британские исследователи сделали интересное открытие: люди перенесшие грипп H1N1, получили «супер–иммунитет», способный противостоять различным штамма...

Выход официального трейлера фильма «Супер 8» запланирован на март 2011г
Джей Джей Абрамс определился с датой выхода в свет официального трейлера своего нового фильма «Супер 8»! Зрители смогут увидеть его уже в марте 2011 г...

Определены суперфиналисты «Х-фактора»
По итогам зрительского голосования, «Х-фактор» покинули Владимир Ткаченко и Александр Кривошапко.Суперфиналситами стали Алексей Кузнецов и Мария Рак.П...

Супер-прививка поможет навсегда сбросить 10 кг
В ближайшее время на рынке может появиться уникальная прививка, помогающая похудеть на два размера всего за шесть месяцев.Данное средство уже успело с...

Открыт "эффект суперплацебо"
Ученые доказали, что эффект плацебо - мнимое лечение препаратом, не имеющим фармацевтического эффекта, - оказывается действенным...

Супермодель Кейт Мосс разработает собственное.. варенье!
В отличие от других звезд шоу-бизнеса, выпускающих коллекции модной одежды и элитных парфумов, Кейт Мосс решила наладить бизнес и получать хороший до...

В жару ставропольцам не советуют покупать еду в супермаркетах
Из-за неправильного хранения продукты становятся опасными для здоровья, передает «КП».Август не принес ставропольцам долгожданной прохлады. Впрочем, с...

Орландо Блум женился на супермодели!
33-летний Орландо Блум покинул ряды самых завидных холостяков Америки. Английский актер(«Властелин колец», «Пираты Карибского моря»)женился на 27-летн...